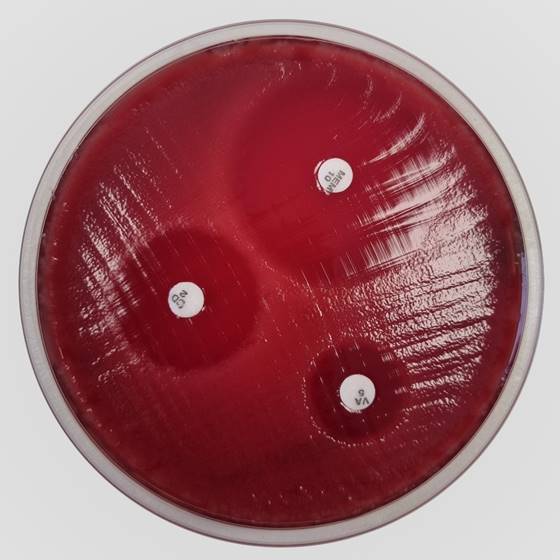

Über das Produkt
Fastidious Anaerobe Agar, Zusammensetzung gem. EUCAST
Zur Empfindlichkeitstestung anspruchsvoller anaerober Bakterien mittels Agardiffusionstest (u.a. Porphyromonas melaninogenicus, Fusobacterium necrophorum, Propionibacterium acne, Bacteriodes fragilis, Eubacterium spp.)